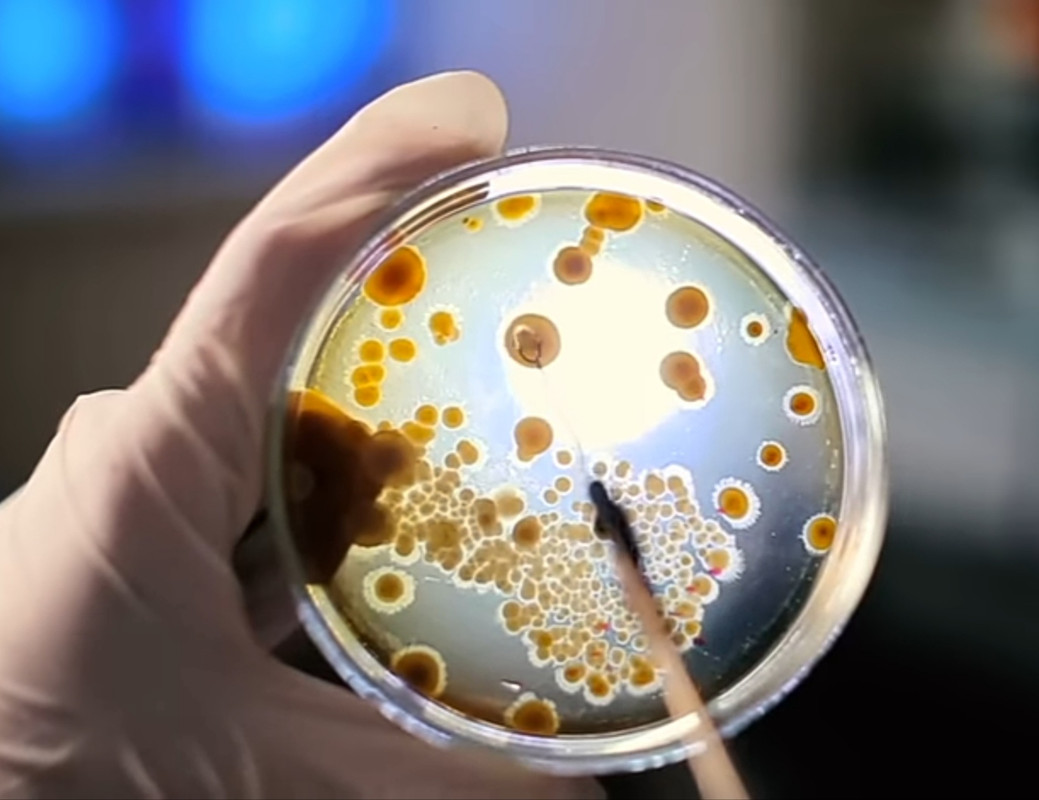

Mind-Blowing Things You Never Knew Were Inside Your Body!
The Human Body: A Natural Factory of Wonders
Despite the immense advancements in medical and scientific research, the human body remains a source of endless wonder. With every new discovery, scientists continue to be amazed by its complexity, revealing how nature has equipped us with capabilities and substances once thought impossible.
Natural Alcohol Production
Every year, around 36 billion liters of alcohol are consumed globally. While excessive alcohol intake can lead to unconsciousness, accidents, and health issues, what’s lesser known is that the human body produces alcohol naturally. Ethanol, the main type of alcohol in alcoholic beverages, can be generated internally by bacteria in the mouth and intestines. These microbes ferment carbohydrates—like sugars and starches—into small amounts of ethanol, which then enter the bloodstream. In healthy individuals who abstain from drinking, each liter of blood may still contain up to 0.8 mg of ethanol.
Rarely, some people experience a condition known as Auto-Brewery Syndrome. Their digestive systems host high populations of fermenting bacteria and fungi, which produce enough alcohol to cause intoxication symptoms—despite the person never consuming alcohol.
Ozone Inside the Body
Ozone is known as a protective layer in Earth's atmosphere, shielding us from harmful ultraviolet rays. Surprisingly, a similar compound is produced by our immune system. Neutrophils, a type of white blood cell, use high-energy oxygen molecules to create ozone as a defense mechanism. This powerful substance helps destroy harmful bacteria and pathogens.
However, too much internal ozone can have negative effects. High concentrations can break down cholesterol, leading to toxic byproducts associated with arteriosclerosis and arthritis.
Cyanide: The Natural Toxin
Cyanide is one of the most infamous poisons in history, yet our bodies naturally produce and process small amounts of it. It’s found in trace levels in the air, water, and certain foods like bitter almonds and apples. These minimal quantities are not harmful and are typically broken down by the body. Cyanide is produced in the saliva through chemical reactions and expelled through breath or urine. An average person carries about 50 micrograms per 100 grams of tissue, which is safely processed by the liver and lungs.
Radioactive Elements in the Body
It might sound alarming, but our bodies also contain radioactive elements. One such element is thorium, commonly used in electronic devices. Like cyanide, it enters the body through water or unwashed foods and is usually expelled in a few days. Even more surprisingly, studies have found traces of uranium—a key component of nuclear energy and weaponry—in the human body. Adults may carry up to 22 micrograms of uranium, mostly from food and water. Two-thirds of the uranium tends to settle in the bones, where it can remain for months before being eliminated.
Precious Metals and Rare Elements
Our bodies also contain trace amounts of precious metals like gold and silver. Gold, for example, is primarily found in the bloodstream, representing about 0.02% of total blood content. Adults may also consume around 88 micrograms of silver daily—roughly the weight of a few grains of sand.
Human waste has been found to contain valuable metals such as gold, copper, and silver, as well as rare earth elements like palladium and vanadium, which are essential in electronics manufacturing. According to a study published in Environmental Science & Technology, the waste from one million people could contain up to $13 million worth of recoverable metals.
Natural Narcotics
Perhaps the most surprising of all is the body’s ability to produce compounds that mimic narcotics. The body generates its own cannabinoids—molecules similar to those in marijuana—and endorphins, which function like morphine. These compounds help manage pain and stress but, when overproduced, can have harmful effects, mirroring the impact of drug addiction.
“Which of these facts about your body that piqued your curiosity? Drop your thoughts below 👇”